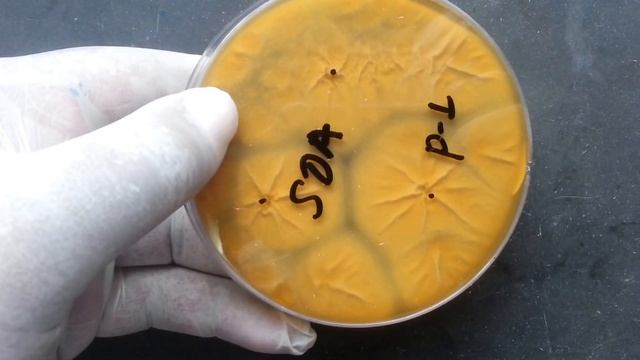
penicillium growth on SDA смотреть онлайн

П
Поиски Грибных Островов
Смотреть все онлайн видео автора канала
 05:24
05:24
Чим харчуються тварини.Вчитель: Конончук Ю.О.mp4
 15:59
15:59
Очередной поход за брусникой и грибами
 14:45
14:45
Candida under the microscope with Gomori's Methenamine Silver (GMS) stain
 00:38
00:38
Мото_17 #мотомосква #мотоподготовка #мотообучение #мотозима #мотоболезнь
 00:33
00:33
ПАСТА С ГРИБАМИ НА КОКОСОВЫХ СЛИВКАХ 🥥
 24:07
24:07
📝 the real struggles of being a small business owner (tips and inspirational talk)
 00:57
00:57
Стадион. «Олимпийские Надежды» в Запорожье передали в аренду. Что будет вместо?
 04:10
04:10
Нарезка #21"Кирилл под Грибами"
 00:43
00:43
Вывал леса под Садовым_всё видео Завьялова1
 01:43
01:43
Opening party - FIRM Barbershop
 01:52
01:52
Слова песни Григорий Лепс - Я верну тебя
 19:15
19:15
Dolores Pinheiro – Acquired azole resistance in Aspergillus
 04:54
04:54
Serangan Fusarium Pada Pisang
 00:10
00:10
Minicen Владивосток
 00:23
00:23
Найти грибы
 00:50
00:50
Приполярная тундра с буровой скважины
 02:57
02:57
Four Sigmatic Mushroom Coffee Review: Cordyceps, Chaga and Lions Mane.
 01:13
01:13
Fungal #2
00:46
00:46
penicillium growth on SDA
 01:16
01:16
Спалил АЛИСУ
 00:07
00:07
Сколько грибов в лесу?
 03:16
03:16
Ирина Семенова - Между Строк
 41:56
41:56
Николай Волосатов — Работа с крэшами библиотек
 04:56
04:56
初学者采蘑菇教学视频 第三集 关于采蘑菇的四个道听途说的理论
Страница 1
Вперед →
Рады Вас приветствовать на ruvideo.click, только у нас в кинотеатре у вас есть возможность сделать выбор из огромного количества и посмотреть интересующие онлайн фильмы. Без регистрации, онлайн и при чем совершенно бесплатно вы здесь можете смотреть любой фильм или видео, без отправки смс сообщений и пустой траты денег, все что необходимо это включить и получать удовольствие от просмотра. Лучшего качества видео вы просто не найдете. У нас база видео контента обновляется ежедневно, и это касается не только фильмов, но и сериалов и телепередач. Мировые премьеры как отечественного так и зарубежного кинематографа появляются на сайте одновременно с выходом в прокат. Доброго времени суток и приятного всем просмотра!
Лучше чем онлайн кинотеатр ULTRADOX!